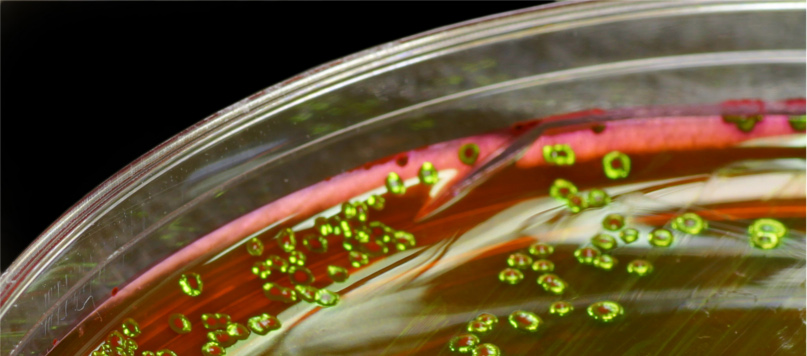

Mikroorganismer er en fellesbetegnelse på organismer som er så små at vi må ha mikroskop for å se dem. Mikroorganismer finnes overalt, også på kroppens ytre (huden) og indre overflater (slimhinner i munnhulen, svelget, nesehulen, nedre deler av urinveiene og vagina).
Kroppens normalflora består av mikroorganismer
For eksempel finnes det milliarder av mikroorganismer i tykktarmen. Tilsammen utgjør alle mikroorganismene på kroppen det vi kaller kroppens normalflora.

Mikroorganismer er en fellesbetegnelse på små organismer
Infeksjonssykdommer
Sykdomsfremkallende organismer kalles patogene organismer. Sykdommene de fremkaller kaller vi for infeksjonssykdommer.
Grupper med mikroorganismer
Vi deler mikroorganismene inn i 5 grupper;
– Bakterier
– Virus
– Sopp
– Encellete dyr (protozoer)
– Parasitter (flercellete patogene organismer kalles parasitter).
Normalfloraen består av bakterier som normalt er ufarlige
Disse utgjør også en del av vårt immnunforsvar. Om disse mikroorganismene havner steder de ikke hører hjemme kan de imidlertid skape sykdom.
Et typisk eksempel er tarmbakterier som kommer opp i urinrøret eller i bukhulen (f.eks E- coli bakterien som er en viktig del av tarmfloraen). Dersom denne kommer opp i bukhulen eller i urinrøret kan den skape infeksjon. I urinrøret kalles det da for urinveisinfeksjon.
Bakterier og virus vanligst i vesten
I vesten er de vanligste infeksjonssykdommene forårsaket av bakterier og virus. I andre deler av verden, som i u- land, er parasitter (flercellete organismer) et stort problem, f.eks malaria.
Noen patogene mikroorganismer kan feste seg på hud eller slimhinner, andre er avhengige av sår, skader eller nedsatt forsvarsevne for å få feste.
Det er vanlig at patogene mikroorganismer kommer via fordøyselsessystemet, mage og tarm. En del bakterier og parasitter får tilgang via insektstikk (for eksempel malaria).
Virus
Virus består av nukleinsyrene DNA og RNA, pakket inn i en proteinkappe. Virus mangler cellemembran, organeller og enzymer som er nødvendig for stoffomsetning, vekst og reproduksjon.
Virus er ikke celler, men de invaderer celler og tar over enzymapparatet og gentranskripsjonen til cellen og produserer nye virus. Virus er altså ikke celler.
Bakterier
Bakterier er selvstendige celler som formerer seg ved celledeling, noe et virus ikke er i stand til.
Immunforsvarets viktigste funksjon
Hovedfunksjonen til immunapparatet er å ta knekken på patogene (fiendtlige) mikroorganismer (bakterier, virus, sopp og protozoer) og parasitter. Med andre ord å stoppe infeksjoner. Dette skjer vanligvis uten at kroppen tar skade.
Ved allergier kan kroppen ta skade av at immunforsvaret reagerer kraftig på mikroorganismer som i seg selv ikke er patogene (skadelige). Dette henvises ofte til som autoimmune sykdommer, der immunforsvaret angriper sin egen kropp.
Immunforsvaret
På de neste sidene går vi igjennom immunforsvaret del for del, og starter med det spesifikke immunforsvaret.
=== >>> Neste side, det spesifikke immunforsvaret
[vc_basic_grid post_type=»page» max_items=»-1″ style=»lazy» items_per_page=»3″ order=»ASC» item=»4988″ initial_loading_animation=»none» grid_id=»vc_gid:1504635649483-c4216c24-6c40-5″ taxonomies=»73″]